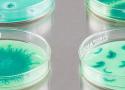

372 shaares
1 résultat
taggé
cadeaux
De l'art associé à de la biologie (de la recherche en biologie, genre électrophorèses, mitochondries, microscopie…)